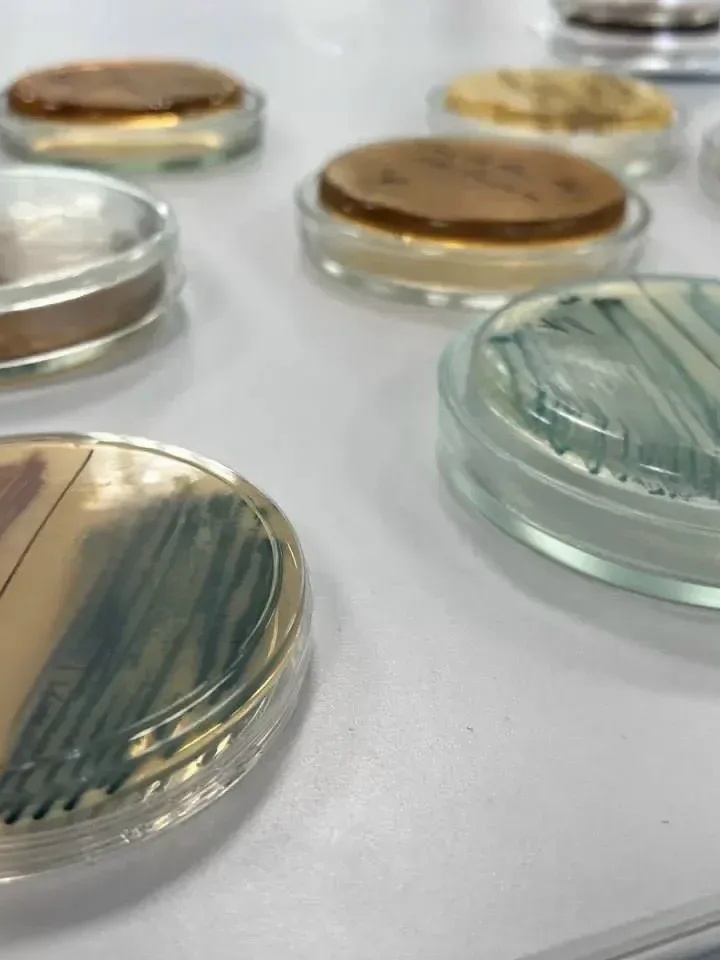
Сегодня среда, а значит... #НаучнаяСреда

Сегодня среда, а значит... #НаучнаяСреда
🧬 Ученые Башкирского ГМУ Минздрава России разработали отечественную тест-систему для выявления «бактерии стройности»
В Лаборатории микробиома человека Башкирского ГМУ Минздрава России создали инновационную тест-систему. Она позволяет быстро и точно определять количество бактерии Akkermansia muciniphila в организме человека.
💡 Эту микрокультуру также называют «бактерией стройности». Она является важным маркером здоровья метаболизма, выполняя роль невидимого регулятора обменных процессов.
↪ Особенности технологии:
🔴 ранее для точного количественного определения бактерии требовалось полногеномное секвенирование — сложный и длительный процесс;
🔴 новая тест-система быстро определяет конкретную бактерию и проводит качественный и количественный анализ.
📌 Технология позволит объективно мониторить эффективность терапии для пациентов с метаболическими нарушениями.
— Мы не просто нашли бактерию, мы нашли применение этому знанию. Тест-система поможет врачам управлять микробиомом для профилактики целого спектра социально значимых заболеваний, — заявил ректор Башкирского ГМУ Минздрава России Валентин Павлов.
💬 Получить MAXимум пользы для здоровья👉https://max.ru/minzdrav_ru
#СделаноВРоссии
#БудущееМедицины